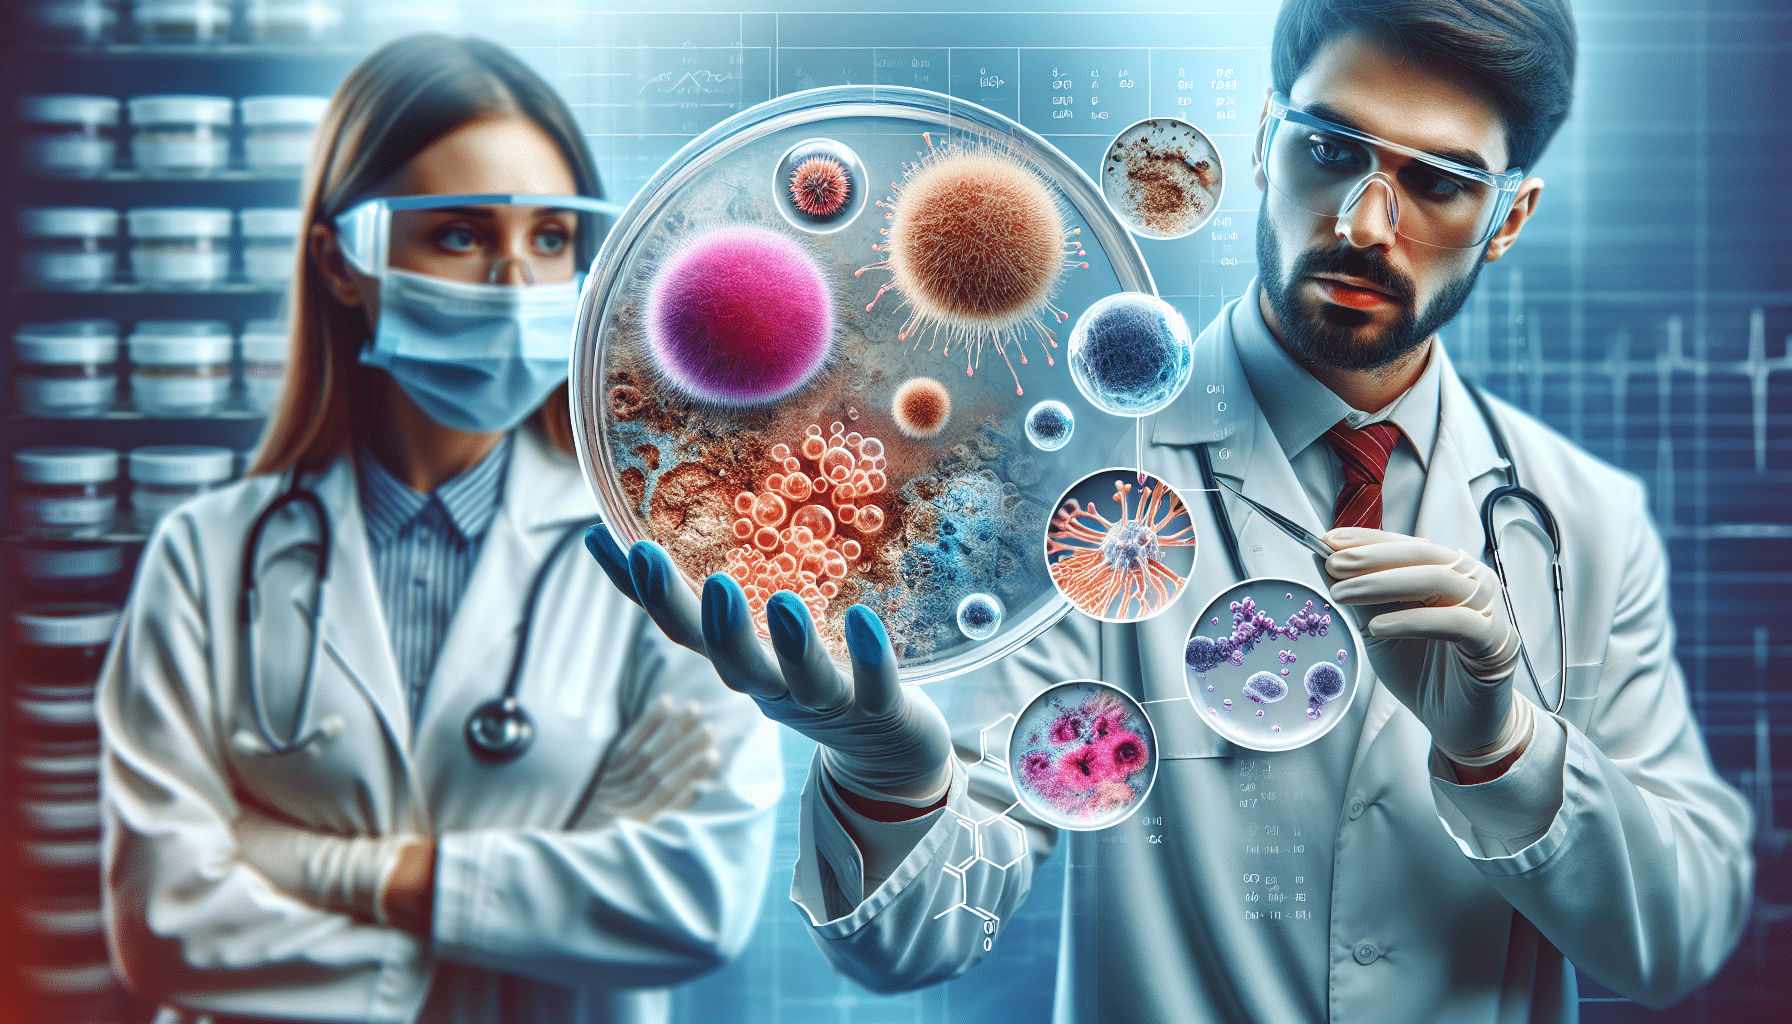
Health Symptoms of Mycotoxin Exposure and Diagnosis Methods - illustrative chart of symptoms, testing options and diagnostic workflow

Exposure And Diagnosis Methods: Health Symptoms Of Mycotoxin
Mycotoxins are toxic chemicals produced by certain moulds that can contaminate food and indoor environments; understanding the Health Symptoms of Mycotoxin Exposure and Diagnosis Methods is essential for anyone deciding whether to test, which test to buy, and how to act on results. This buyer’s guide focuses on the specific symptoms linked to mycotoxin exposure, the strengths and limits of available diagnostic approaches, and practical buying and testing advice for homeowners and facility managers in Dubai, Abu Dhabi, Sharjah, Ajman, Fujairah, Ras Al Khaimah, Riyadh and Jeddah.
Understanding Health Symptoms of Mycotoxin Exposure and Diagnosis Methods
Before purchasing tests or starting detox plans you must understand what symptoms mycotoxins typically produce and what each diagnostic method can (and cannot) show. Health Symptoms of Mycotoxin Exposure and Diagnosis Methods overlap: symptom patterns guide which tests make sense, while test outcomes must be interpreted in the clinical and environmental context.
Common Health Symptoms Linked to Mycotoxin Exposure
Different mycotoxins cause different effects, but several symptom clusters recur in human exposures and in published reviews. Use these symptom clusters to prioritise testing and clinical referral.
Neurological and cognitive
Brain fog, poor memory, difficulty concentrating, headaches, dizziness and mood changes are frequently reported in people who suspect mould-related illness; persistent cognitive symptoms warrant combined clinical assessment and targeted testing because they may have multiple causes.
Fatigue and post-exertional malaise
Unexplained chronic fatigue, low energy and worsening after exertion are common complaints and often prompt urine mycotoxin testing among symptomatic patients.
Respiratory and ENT
Chronic rhinitis, sinusitis, cough, wheeze and asthma exacerbation may follow inhalation exposure to moulds or contaminated dust; however, respiratory symptoms are non-specific and require environmental assessment to link to mycotoxins. This relates directly to Health Symptoms Of Mycotoxin Exposure And Diagnosis Methods.
Gastrointestinal
Abdominal pain, nausea, vomiting and diarrhoea can result from acute ingestion of mycotoxin‑contaminated food and are classical features of foodborne mycotoxicoses.
Immune, dermatological and systemic
Recurrent infections, increased allergy symptoms, rashes, hives and unusual inflammatory patterns have been associated with chronic exposures and immune modulation by some mycotoxins.
Renal and hepatic signals (toxic endpoints)
Certain mycotoxins (e.g., ochratoxin A) have demonstrated kidney effects in animals and are suspected of contributing to renal dysfunction; aflatoxins are hepatotoxic and carcinogenic with long-term exposure risk, emphasising why laboratory confirmation matters for public health decisions and treatment planning.
Acute vs Chronic: Health Symptoms of Mycotoxin Exposure and Diagnosis Methods
Distinguish acute mycotoxicosis from chronic low-dose exposure because diagnostic strategy differs.
Acute mycotoxicosis
Acute poisoning from contaminated food often produces rapid gastrointestinal distress, fever and sometimes neurological signs; diagnosis is clinical plus laboratory confirmation of mycotoxins in leftover food or biological samples when available. When considering Health Symptoms Of Mycotoxin Exposure And Diagnosis Methods, this becomes clear.
Chronic exposure
Low-dose long-term exposures present with non-specific systemic symptoms (fatigue, cognitive changes, immune dysfunction) and require careful biomonitoring and environmental investigation to link cause and effect.
Diagnosis Methods Overview: Health Symptoms of Mycotoxin Exposure and Diagnosis Methods
There are two broad diagnostic strands: environmental testing (food, dust, surface, air) and biological monitoring (urine, blood, tissue adducts). Each method answers different questions and costs differ substantially.
Environmental testing (food and indoor)
Food testing: LC‑MS/MS is the regulatory gold standard for multi‑mycotoxin quantification in food and is used by public agencies and accredited labs for reliable results; the FDA uses validated LC‑MS/MS for many mycotoxins in food matrices which offers high sensitivity and specificity.
Dust and air testing: DNA-based panels (e.g., ERMI/HERTSMI‑2) and dust mycotoxin assays can provide a whole‑house perspective but represent historical exposure and may not reflect current airborne concentrations or ingestion risk.
Biological monitoring
Urine mycotoxin testing detects parent toxins or metabolites and is used to assess recent body burden; methods include targeted LC‑MS/MS and immunoassays used by commercial labs. Urine results show exposure but not necessarily causation of symptoms, and timing, metabolism and detox status influence findings. The importance of Health Symptoms Of Mycotoxin Exposure And Diagnosis Methods is evident here.
Blood biomarkers and DNA or protein adducts (e.g., aflatoxin‑DNA adducts) are more specific for certain mycotoxins and useful in epidemiology and risk assessment but are less available for routine clinical use.
Clinical laboratory tests
Routine clinical tests (liver enzymes, renal function, complete blood count, inflammatory markers) are essential to evaluate organ damage and to rule out other diagnoses; specialised toxicology panels may assist in targeted cases.
How to Choose Mycotoxin Tests — A Buyer’s Guide
Choosing the right test depends on your objective: confirm clinical exposure, identify contaminated food, or evaluate an indoor environment. Use the following checklist when deciding what to buy.
- Define the goal: clinical assessment (body burden), food safety (single item), or environment-wide (house dust/air).
- Prefer LC‑MS/MS for accuracy: For food and clinical confirmation choose labs using validated LC‑MS/MS methods (regulatory standard) rather than only immunoassays; the FDA endorses LC‑MS/MS methods for multi‑mycotoxin analysis in food.
- Understand sample requirements: Urine collection timing, food sample quantity, dust sampling protocol and preservation matter for valid results.
- Look for accredited labs: Choose laboratories with recognised accreditation or transparent validation data and clear limits of detection.
- Check turnaround time and support: Buy tests that include interpretative reporting and clinician/technical support; raw numbers without context are often misleading.
- Budget realistically: Expect higher cost for LC‑MS/MS and multi‑analyte panels; in the UAE region, factor in shipping to accredited international labs if local capacity is limited.
When to start with inexpensive tests
For preliminary environmental screening, culture plates or surface swabs and visual inspection are low cost and may guide whether escalation is needed; however, these are not substitutes for definitive LC‑MS/MS food or urine testing when clinical stakes are high.
Common Mistakes and How to Avoid Them
Avoid these frequent errors when evaluating Health Symptoms of Mycotoxin Exposure and Diagnosis Methods to prevent false reassurance or unnecessary expense.
- Misinterpreting a positive urine result: A detectable mycotoxin means exposure occurred, not automatically that it causes symptoms; correlate with clinical findings and environmental evidence.
- Relying on single tests: Don’t base decisions on one sample or a single household dust test—repeat or combine with food testing, clinical labs and an environmental inspection when needed.
- Skipping environmental source identification: Biological positives without locating exposure sources lead to recurrence; always pair body monitoring with thorough environmental investigation.
- Using non‑validated home kits for critical decisions: Cheap home kits can detect presence/absence but often lack sensitivity and specificity; for food safety or clinical action, use validated lab methods.
- Ignoring confounders: Consider medications, diet, occupational exposures and pre‑existing illnesses that can mimic or modify symptoms.
Recommended Test Options and Practical Buying Tips
Below are practical recommendations for each diagnostic need and what to look for when purchasing tests in the Gulf region.
For food testing
Buy an accredited laboratory service that offers validated LC‑MS/MS multi‑mycotoxin panels; choose labs that accept small food samples and provide a clear report including limits of detection and regulatory thresholds. Expect costs to vary—obtain quotes in AED and include shipping if samples are sent abroad.
For body burden (urine) testing
Select laboratories that use LC‑MS/MS and provide metabolite analysis for key mycotoxins (ochratoxin A, aflatoxins, trichothecenes, fumonisins, zearalenone). Ensure sample collection instructions are clear (first morning urine or 24‑hour collection as specified).
For environmental screening
Use a tiered approach: visual inspection and moisture mapping (thermal imaging and moisture meters), targeted surface and air sampling (spore traps) and dust DNA or mycotoxin dust tests for whole‑house assessment. For serious cases hire a qualified inspector experienced in hygrothermal issues common to Gulf buildings.
Suppliers and services to prioritise
- Accredited regional food testing labs or international labs that publish method validation (LC‑MS/MS).
- Clinical toxicology labs offering urine LC‑MS/MS panels and clinician support.
- Indoor environmental consultants with microbiology capability and hygrothermal diagnostics for the Gulf climate.
Integrating Diagnostics with Clinical Care and Follow-up
Testing is only useful when linked to clinical interpretation and environmental action. Use this integrated workflow when results are positive or symptoms persist. Understanding Health Symptoms Of Mycotoxin Exposure And Diagnosis Methods helps with this aspect.
- Clinical baseline: Start with a physician review and standard blood/urine tests to assess organ function and exclude common conditions.
- Targeted biomonitoring: Order urine or blood mycotoxin testing if clinical suspicion persists after initial workup.
- Environmental investigation: Commission a home/food inspection with validated sampling if biological tests show exposure or if multiple occupants are symptomatic.
- Remediation and prevention: Remove contaminated food, fix moisture issues, clean or replace HVAC components as necessary and document the interventions with post‑remediation testing.
- Follow-up monitoring: Use repeat biological testing and environmental sampling to confirm exposure reduction and clinical improvement.
Expert Tips and Key Takeaways
- Use method‑appropriate tests: For food and clinical confirmation favour LC‑MS/MS; for preliminary home screening use targeted dust or air sampling.
- Combine evidence streams: Symptoms + biological marker + environmental source = stronger case for causation.
- Beware of false certainty: A negative test does not prove absence of exposure—sampling timing, metabolism and analytical limits all affect results.
- Budget for quality: Spending more on validated lab methods and qualified inspectors reduces the risk of repeated remediation and wasted expense; obtain price quotes in AED and factor logistics if using international labs.
- Choose local expertise: For the UAE and Saudi contexts prioritise consultants who understand AC‑driven hygrothermal issues and local storage/food supply routes common to the region.
Conclusion: Health Symptoms of Mycotoxin Exposure and Diagnosis Methods
Health Symptoms of Mycotoxin Exposure and Diagnosis Methods require a systems approach: recognise symptom clusters (neurological, fatigue, respiratory, GI, renal/hepatic signals), select tests that match your objective (LC‑MS/MS for food and clinical confirmation; dust and DNA for environmental mapping), and avoid single‑measure thinking. Combine clinical care, validated laboratory testing and a thorough environmental investigation to protect health effectively in Dubai, Abu Dhabi, Sharjah, Ajman, Fujairah, Ras Al Khaimah, Riyadh and Jeddah.






